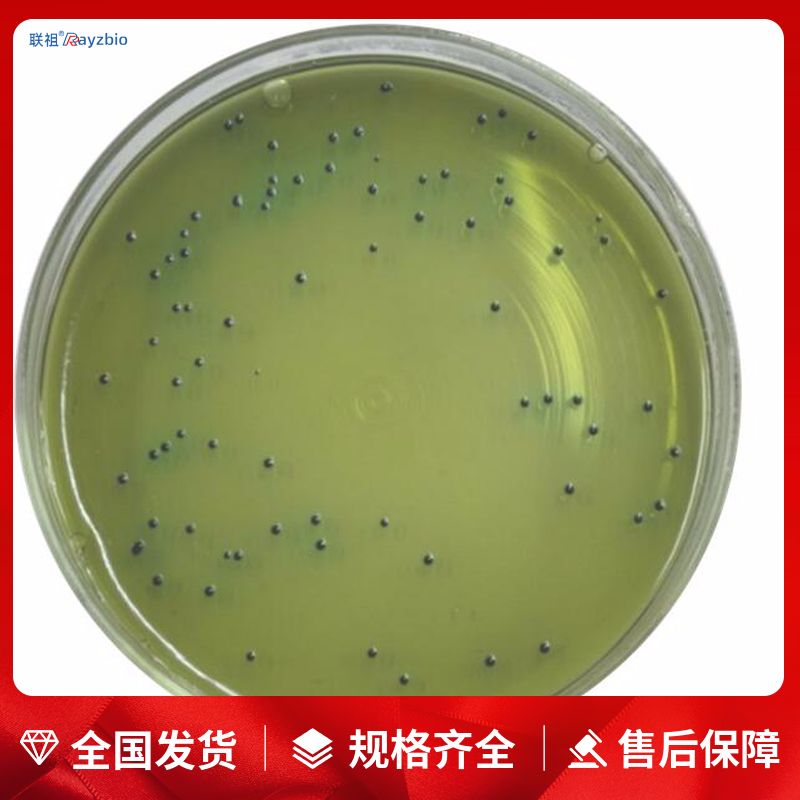
APT肉汤

万千商家帮你免费找货
0 人在求购买到急需产品
- 详细信息
- 技术资料
- 库存:
36
- 英文名:
APT Broth
- 供应商:
上海联祖
- 规格:
250g
| 中文名称 | APT肉汤 | 英文名称 | APT Broth |
| 产品规格 | 250g | 发货周期 | 1~3天 |
| 货号 | LZ-PYJ4133 | 用途 | 仅供科研实验 |
用途:用于异质发酵乳酸杆菌和其它需高含量盐酸硫酸胺素菌的培养。
用法:称取本品46.2g,加热溶解于1000ml蒸馏水中,分装,121℃高压灭菌15min,备用。
质量控制方法:乳酸杆菌。
简便 大多数无需高压灭菌即可使用
特异 目标菌落色泽鲜艳,易于辨识
可靠 经大量分离株验证,符合率高
快速 最快检测时间为24h
节省 大批量样本的处理和检测,可减少补充生化试验的时间和费用
标准化 显色培养基已经普遍得到FDA、AOAC等国外官方的认可,被逐步引入到各种国际和国家检验标准中
一、培养基颜色不正确
(1)含有酸碱指示剂的培养基,若颜色不正确,通常是由于pH不正确导致的,加热过度、错误的灭菌方式等都会导致此项问题。
(2)加热过度导致某些成分分解或糖焦化,如SC培养基(SC增菌液)加热过度会变红,含糖量高的培养基,加热过度通常会出现颜色加深,呈焦糖色或棕褐色。
(3)某些成分变质,如血液久置易变黑,制成的平板颜色偏棕黑色。
二、 培养基不凝固或凝固性差
(1)称量错误
(2)琼脂分布不均匀
(3)培养基pH不正确
(4)加热过度
(5)琼脂量不足
三、培养基产生沉淀
(1)某些培养基原本就含有不溶性沉淀,如TTB,MC培养基等,配方中含有大量不溶性碳酸钙。
(2)灭菌前未充分溶解,如Fraser培养基中含有大量磷酸盐,若灭菌前溶解不充足,灭菌后就会出现大量沉淀。
(3)pH不正确,偏酸或偏碱都有可能使培养基中的部分金属离子产生沉淀。
(4)水的纯度不够,天然水中含有较多的矿物盐离子,若未除净,则易与培养基中的磷酸盐反应生成沉淀。
(5)添加剂加入温度不正确,卵黄、血液等对温度敏感的添加成分,若加入时温度过高或温差过大,易出现凝块。
(6)称量错误。
(7)试剂加入顺序不正确。
体液乙酰酯酶活性荧光法定量检测试剂盒
通用型乙酰酯酶活性化学发光法定量检测试剂盒
细胞乙酰酯酶活性化学发光法定量检测试剂盒
组织短链烯脂酰水合酶(ENOYL COA HYDRATASE)活性比色法定量检测试剂盒
组织中链烯脂酰水合酶(ENOYL COA HYDRATASE)活性比色法定量检测试剂盒
PAP ELISA Kit
vWF ELISA Kit
FⅩ ELISA Kit
FⅨ ELISA Kit
FⅧ-Ag ELISA Kit
通用型甘油三酯(triglyceride)含量酶连续循环反应比色法
体液镁离子(Mg)浓度酶反应光谱法定量检测试剂盒
血液镁离子(Mg)浓度酶反应光谱法定量检测试剂盒
Protocadherin Alpha 6(PCDHa6)ELISA Kit FAKD3 Antibody Blocking Peptide
Amelotin(AMTN)ELISA Kit CD151 Antibody Blocking Peptide
Isocitrate Dehydrogenase 2, mitochondrial(IDH2)ELISA Kit Fibulin 5 Antibody Blocking Peptide
Amylase Alpha 2, Pancreatic(AMY2)ELISA Kit FADS6 Antibody Blocking Peptide
Oxidative Stress Induced Growth Inhibitor 1(OSGIN1)ELISA Kit RGMA Antibody Blocking Peptide
Cholinergic Receptor, Nicotinic, Beta 3(CHRNb3)ELISA Kit ATF5 Antibody Blocking Peptide
Platelet Derived Growth Factor AB(PDGFAB)ELISA Kit SMG6 Antibody Blocking Peptide
Heme Oxygenase 1, Decycling(HO1)ELISA Kit DEX Antibody Blocking Peptide
Vascular Endothelial Growth Factor C(VEGFC)ELISA Kit F2RL3 Antibody Blocking Peptide
Thymic Factor(TF)ELISA Kit PACAP Antibody Blocking Peptide
Semaphorin 6A(SEMA6A)ELISA Kit ARSI Antibody Blocking Peptide
Cardiotrophin 1(CT1)ELISA Kit DUSP16 Antibody Blocking Peptide
Adenylate Kinase 2(AK2)ELISA Kit Human ox-LDL
Creatine Kinase, Mitochondrial 1A(CKMT1A)ELISA Kit Recombinant human ST2 protein, His
Cyclin Y(CCNY)ELISA Kit TIMM50 Antibody Blocking Peptide
Suppressors Of Cytokine Signaling 3(SOCS3)ELISA Kit SBDS Antibody Blocking Peptide
DihydroarteMisinic acid
Steviolbioside
Dehydroevodiamine
D-Pinitol
APT肉汤甘露醇卵黄多粘菌素琼脂平板(9cm) Mannitol-Egg-Yolk-Polymyxin Agar Base 10个/包
BCYE-CYS琼脂平板(9cm) BCYE-CYS Agar 10个/包
改良CCDA琼脂平板(9cm) Modified CCDA Agar 10个/包
风险提示:丁香通仅作为第三方平台,为商家信息发布提供平台空间。用户咨询产品时请注意保护个人信息及财产安全,合理判断,谨慎选购商品,商家和用户对交易行为负责。对于医疗器械类产品,请先查证核实企业经营资质和医疗器械产品注册证情况。
技术资料暂无技术资料 索取技术资料
APT肉汤
¥600 - 3200